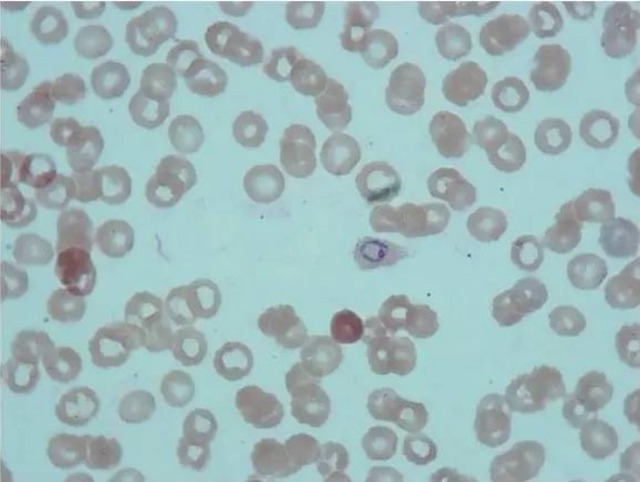
plasmodium

plasmodium

plasmodium vivax
图片尺寸1129x770
identification of piggybac-mediated insertions in plasmodium
图片尺寸1044x536
plasmodium vivax
图片尺寸655x480
plasmodium life.jpg
图片尺寸543x430
plasmodium
图片尺寸640x482
interrupting the lifecycle of the plasmodium falciparum parasite
图片尺寸700x540
疟原虫plasmodiumspp
图片尺寸511x623
plasmodium vivax: blood stage parasites thin blood smears
图片尺寸558x757
red blood cell stages of plasmodium vivax02
图片尺寸492x433
the epidemiology of plasmodium vivax: history, hiatus and hubris
图片尺寸515x768
plasmodium vivax
图片尺寸635x855
atorvastatin prevents plasmodium falciparum cytoadherence and
图片尺寸838x1104
疟原虫如何躲避众多药物的攻击
图片尺寸700x525
新疆罕见输入性非洲卵形疟原虫感染1例报告
图片尺寸640x927
other cns
图片尺寸500x375
protozoan parasite known by its genus name, plasmodium
图片尺寸800x420
plasmodium infection inhibits the expansion and activation of
图片尺寸785x501
【预售 按需印刷】plasmodium co-infection and hiv infection
图片尺寸907x1360
binding of quinoline-based inhibitors to i>plasmodium
图片尺寸2372x3443
英文原版 the epidemiology of plasmodium vivax: history
图片尺寸800x800